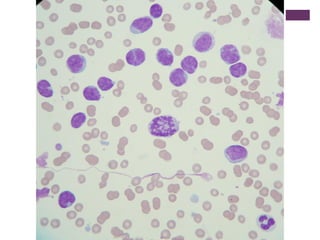

O documento descreve um caso clínico de uma cadela com pancitopenia persistente após tratamento prolongado com antibióticos para infecções urinárias recorrentes. O mielograma mostrou hipocelularidade medular grave com diseritropoiese moderada e grave disgranulopoiese, sugerindo toxicidade medular pelos antibióticos como causa provável da pancitopenia.